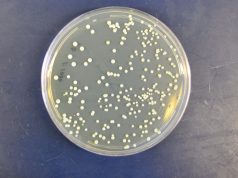
Piccolo database dei lieviti by BrewingBad

Le 12 migliori ricette pubblicate sul blog. L’ordine di apparizione in classifica è casuale.
Belgian Saison
Ah, se potessi avere dieci euro per ogni cotta di Saison sbagliata nella mia vita di homebrewer (spolier: ora avrei circa 40€ in più). Scherzi a parte, il mio personale percorso per riuscire a produrre una Saison decente è stato lungo. La rivelazione è arrivata quasi per caso, quando ho lasciato cinque litri di mosto inoculati con il lievito Belgian Saison senza controllo di temperatura in un periodo piuttosto caldo. Il risultato è stato sorprendente: una birra in stile, elegante, rustica, godibilissima. Per sicurezza ho riprovato a brassare la birra con lo stesso profilo di fermentazione (stavolta in camera di fermentazione) con un buon risultato. Entra quindi con merito nella top 10 delle migliori birre che abbia mai prodotto (ne esiste anche una versione session).
Flotsam & Jetsam / American Porter
Birra nata inizialmente come “svuotadipsensa” e rielaborata successivamente secondo una ricetta ragionata con meno ingredienti. Venuta molto bene, ha ricevuto diversi riscontri positivi da amici anche piuttosto esperti. Il bilanciamento e la base maltata secondo me sono solidi, la luppolatura si può variare seguendo il proprio gusto.
Fyne By Me / British Golden Ale
La mia birra del cuore, ispirata alla Jarl di Fyne Ales. Ricetta semplicissima con un solo luppolo, l’ottimo Citra. Miracolosamente non si è ossidata, il colore è sempre rimasto brillante (per quel che è durata). Ha retto abbastanza bene il confronto testa a testa con l’originale.
Humble Bastard / American Strong Ale
Altra produzione ispirata a una birra commerciale: la Arrogant Bastard di Stone, che diversi anni fa aprì il mio cuore al birrificio di Greg Koch. Questa è la seconda versione della mia ricetta, leggermente modificata rispetto alla prima. Risultato più che discreto, anche bevuta al fianco dell’inarrivabile originale.
Bojack / Tripel
Si dice che le Tripel siano uno degli stili più difficili da produrre, sia in casa che in birrificio. Non so quanto questo sia vero, ma posso affermare senza dubbio che farne una buona non è affatto facile. È uno stile in cui il lievito è il protagonista, con un profilo aromatico complesso ma allo stesso tempo delicato che unisce mille sfumature organolettiche in una combinazione dagli equilibri delicatissimi. Ho provato tre volte a brassare una Tripel: la prima (senza nome) era completamente da dimenticare; la seconda (chiamata Bojack) piacevole ma con qualche difetto e non ancora centrata; la terza mi ha davvero sorpreso. Ecco a voi la Bojack Tripel V2.
Roight! / Irish Stout
Ed eccoci alla ricetta che più ho affinato in questi anni di produzione casalinga. Amo l’Irlanda, da sempre: oltre ad aver vissuto un anno a Dublino dopo la laurea, l’ho girata in lungo e in largo per anni. Mi manca, tornerei a viverci domani se potessi. Riesco saltuariamente a consolarmi con una pinta di Irish Stout al bancone di qualche pub romano, quando riesco a trovarne di ben fatte (tipo la Gallagher Stout di Hilltop Brewery). Questa mia ricetta è arrivata alla quarta versione, con piccoli affinamenti successivi. Direi che dopo tanto lavoro decisamente ci siamo. Slainte!
Cuppocoffee / Irish Extra Stout
Siamo ancora in Irlanda, con una sorta di versione pompata di una Irish Stout: più alcol, più tostato, più amaro. In questa ricetta ho sperimentato per la prima volta il malto Brown. Ricordo che ne diedi una bottiglia a Samuele Cesaroni di Brasseria della Fonte (prima che diventasse famoso per le sue grandiose stout) e rimase molto colpito. Ed è uno che non si lascia andare a complimenti se non è convinto (ricordo che in quella stessa occasione gli diedi anche una IPA secondo me venuta abbastanza bene, su cui glissò educatamente).
Resident Drunk / Foreign Extra Stout
Non potevo far altro che chiudere la saga delle stout di stampo irlandese. Anche se per il BJCP le Foreign Extra Stout sono classificate come birre inglesi, per me rappresentano la versione più alcolica e muscolosa delle Irish Stout: tostate e secche, con un tasso alcolico che si fa sentire ma non stanca. Di questa birra sono particolarmente orgoglioso, mi ha quasi steso la sera di Natale quando la avevo attaccata alla spina.
Altnaharra / Strong Scotch Ale
Il nome impronunciabile di questa birra è quello di un paesino disperso nelle Highlands scozzesi. Definirlo paesino è anche esagerato, visto che in pratica è un albergo davanti a due pompe di benzina con quattro case intorno. Ci fermammo per una birra durante un giro di una ventina di giorni per la Scozia in tenda. Eravamo diretti altrove ma a un certo punto, stanchi di guidare, ci siamo detti: una pinta sola e poi si va avanti. Ci siamo risvegliati la mattina dopo nella tenda piantata (male) nel prato dell’albergo, dopo aver suonato, partecipato a una festa in una casa vicino e mangiato tramezzini di cervo tutta la sera. Ricordo vagamente che a fine serata svuotavamo le ultime bottiglie di birra che ci offrivano, senza farci vedere, nel vaso di una pianta all’angolo del salone di questa fantomatica casa (non ce la facevamo più a bere).
Questa birra è poi diventata la Wallace, che è stata prodotta da Eastside e venduta per due stagioni di seguito al Jolly Roger di Fregene.
East Of The Rhine / Altbier
Nel corso dei miei viaggi in Europa sono arrivato fino a Colonia a bere Kölsch, ma non ho avuto – ahimè – occasione di incrorciare Düsseldorf per assaggiare l’altro grande esempio di alta fermentazione tedesca: le Altbier. Per fortuna, qui a Roma ogni tanto se ne trova qualche botticella in giro per pub, oltre alle diverse interpretazione prodotte da validi birrifici italiani. Mi ci sono voluti due tentativi (il primo abbastanza lontano dall’obiettivo) prima di arrivare a un risultato che mi soddisfacesse. Questa birra mi è piaciuta davvero molto: ispirata alla Uerige, la più maltata e amara tra le interpretazioni di questo stile, mostra un discreta intensità maltata ben equilibrata dalla luppolatura in amaro.
Sweet Euphoria / India Pale Ale
Un IPA “vecchio stile”, prodotta con metodo classico prima che abbracciassi le pratiche della contropressione. Venuta molto bene, resinosa e agrumata senza troppe piacionerie tropicali. Come le IPA di un tempo, quelle che noi della prima generazione delle luppolate d’oltreoceano apprezziamo ancora molto.
Talkin shite in the pub / Dark Mild
Uno stile della tradizione inglese poco diffuso in Italia, che fa fatica a trovare spazio tra le spine a pompa dei pub anche in Inghilterra. Avevo provato a farne una versione qualche anno fa con risultati mediocri, questa nuova interpretazione prodotta nel 2019 mi ha dato molta soddisfazione.
Menzione d’onore / Puzzetta Sour Ale
Questa birra non entra nella top ton perché è stata una produzione one-shot di cui non esiste una vera e propria ricetta. A un certo punto feci due cotte molto vicine tra loro con un grist di frumento e malto pils da dedicare a birre acide. L’idea era mettere su una sorta di “cantina acida” al box del mio amico Raffaello, per fare dei blend. Mi fermai alla seconda cotta e l’esperienza finì con due damigiane da cinque litri più un fermentatore in plastica da dieci litri lasciati al box per quasi due anni. La fermentazione primaria la feci con lieviti “normali”, poi ho aggiunto vari altri microbi (da questo post potete leggere tutto il percorso). La fortuna mi portò a ottenere birre diverse tra loro: quelle in damigiana eccessivamente acide, quella nel fermentatore molto delicata. Mi rinchiusi al box un pomeriggio e tentai un blend dopo vari assaggi. Ne uscì una birra molto interessante ed equilibrata, che purtroppo non ce la fece mai a carbonare. Puzzetta, dedicata alla piccola Emma che era nata da pochi mesi quando imbottigliai il blend.

Mamma mia che ricordi mi hai riportato alla mente!!
Era il periodo in cui vivevo a Lione e leggevo il blog andando al lavoro in bus.
Quanta compagnia mi hai fatto in quei 45 minuti di tragitto! A volte, quando ero nel bel mezzo di un articolo interessante mi scocciava interrompere e dover scendere alla mia fermata 😉
Grazie, che gran piacere!